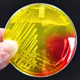

Research Projects
Developing Therapeutics to Treat Widespread Cutaneous Viral Infections in Atopic Dermatitis Patients
 Recurrent and widespread viral skin infections, especially with herpes simplex, molluscum contagiosum or vaccinia virus are complications uniquely observed in patients with atopic dermatitis (AD). Ideally, one would like to prevent these from occurring rather than reactively managing them when they arise, as they can result in significant morbidity and even mortality (eczema vaccinatum – vaccinia virus).
Recurrent and widespread viral skin infections, especially with herpes simplex, molluscum contagiosum or vaccinia virus are complications uniquely observed in patients with atopic dermatitis (AD). Ideally, one would like to prevent these from occurring rather than reactively managing them when they arise, as they can result in significant morbidity and even mortality (eczema vaccinatum – vaccinia virus).
Epicutaneous Vaccine Delivery Utilizing Tight Junction Disruption
 Individuals with atopic dermatitis have an impaired skin barrier function and as a corollary have increased sensitization to a wide range of environmental antigens/allergens. Our laboratory identified that the disruption of a junctional complex called tight junctions (TJ) may be responsible for this barrier defect. Harnessing these observations, we developed several TJ disrupting peptides that transiently induce barrier disruption in the skin.
Individuals with atopic dermatitis have an impaired skin barrier function and as a corollary have increased sensitization to a wide range of environmental antigens/allergens. Our laboratory identified that the disruption of a junctional complex called tight junctions (TJ) may be responsible for this barrier defect. Harnessing these observations, we developed several TJ disrupting peptides that transiently induce barrier disruption in the skin.
Learn more about Epicutaneous Vaccine Delivery Utilizing Tight Junction Disruption
Role of S. aureus virulence factors in promoting epidermal viral infectivity: Relevance for atopic dermatitis
Patients with atopic dermatitis (AD) are commonly colonized on their skin with Staphylococcus aureus (S. aureus). The presence and abundance of S. aureus correlates with disease severity. This information coupled with fact that AD patients experience recurrent and widespread cutaneous viral infections, lead us to hypothesize that S. aureus virulence factors may enhance epithelial viral infectivity and promote viral spread.
Patients with atopic dermatitis (AD) are commonly colonized on their skin with Staphylococcus aureus (S. aureus). The presence and abundance of S. aureus correlates with disease severity. This information coupled with fact that AD patients experience recurrent and widespread cutaneous viral infections, lead us to hypothesize that S. aureus virulence factors may enhance epithelial viral infectivity and promote viral spread.
Understanding the Spatial Relationship Between Dendritic Cells and Tight Junctions in the Human Epidermis
 Although disruption of epidermal tight junctions (TJs) is thought to promote immunological responses to epicutaneous antigens or allergens, the physical relationship between TJs and skin resident dendritic cells is still poorly understood. We stain whole-mount human epidermis to investigate the spatial relationship between TJs structure and antigen presenting cells, including dendritic cells (DCs) and the main epidermal dendritic cells called Langerhans cells (LCs).
Although disruption of epidermal tight junctions (TJs) is thought to promote immunological responses to epicutaneous antigens or allergens, the physical relationship between TJs and skin resident dendritic cells is still poorly understood. We stain whole-mount human epidermis to investigate the spatial relationship between TJs structure and antigen presenting cells, including dendritic cells (DCs) and the main epidermal dendritic cells called Langerhans cells (LCs).
Interaction between Staphylococcus aureus and commensal bacteria on the Skin of Patients with Atopic Dermatitis
 Skin microbiome studies of subjects with atopic dermatitis (AD) and healthy individuals, have consistently reported an inverse relationship between the relative abundance of Staphylococcus aureus (S. aureus), which is increased on the skin surface of AD subjects, and several of the major skin commensal bacteria. This leads us to investigate potential interactions between S. aureus and these commensals.
Skin microbiome studies of subjects with atopic dermatitis (AD) and healthy individuals, have consistently reported an inverse relationship between the relative abundance of Staphylococcus aureus (S. aureus), which is increased on the skin surface of AD subjects, and several of the major skin commensal bacteria. This leads us to investigate potential interactions between S. aureus and these commensals.